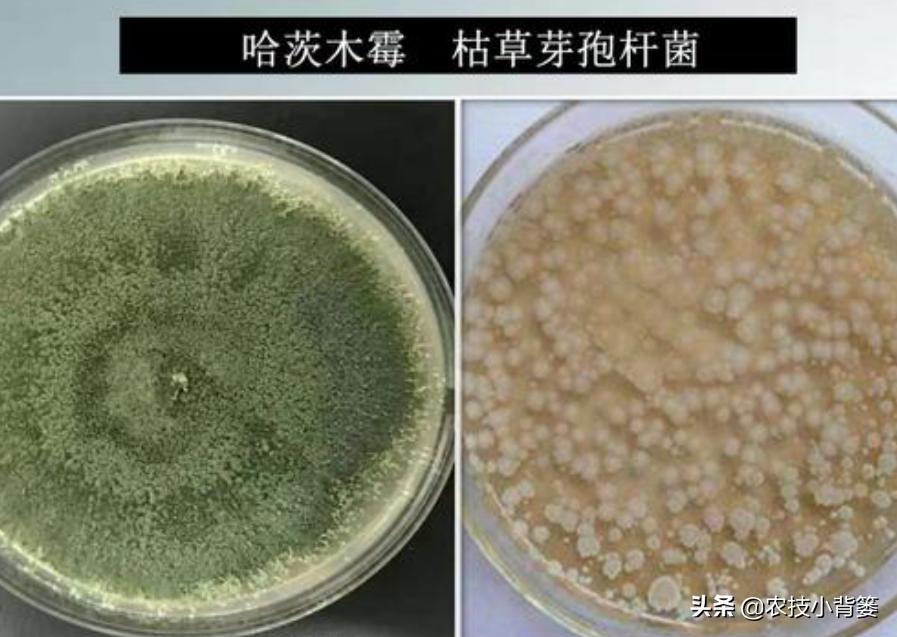
哈茨木霉菌跟枯草芽孢杆菌哪个好,哈茨木霉菌和枯草芽孢杆菌的作用

我们种植瓜果蔬菜时,非常容易发生各类病害,尤其是长期重茬种植、土壤条件不良的种植地,在瓜果蔬菜苗期就非常容易出现烂根、死棵、死苗的问题。

在瓜果蔬菜的病虫害、烂根死苗以及土传病虫害防治上,我们常用的防治方法主要有以农业防治、物理防治、化学防治、生物防治等几种,农业防治的方法主要有选用抗病品种、无病育苗、清理田园、土壤深翻灭茬、土地轮茬间作、调整播种期、合理栽种的密度与深度、科学化水肥管理、植株整枝打杈、及时采收等,物理防治的常用方法主要土壤高温消毒、温汤浸种杀菌、深耕换土、清理病株病体、人工捕杀、物理诱杀(如黄/蓝黏油板、信息诱杀剂、黑光灯、糖醋溶液)、物理驱避(如银色地膜、防虫网)以及大棚通风/采光/遮阳/保温等措施,化学防治的主要方法就是喷打杀菌剂、杀虫剂,生物防治当前最常用的方法是一种是使用生物农药/生物源农药(如青枯立克、苦参碱、印楝素、香菇多糖、氨基寡糖素等)、使用天敌捕食或抑制,另一种是以菌治菌、以菌治虫、以菌防治病虫害。

而今天农技小背篓给大家要说的就是这以菌防治病虫害的生物防治知识。对于大部分农民朋友来说,一提到生物防治,首先想到的就是使用菌肥或菌剂,而提到菌肥或菌剂,绝大数人脑子里首先联想到的就是哈茨木霉菌和枯草芽孢杆菌。
诚然,哈茨木霉菌和枯草芽孢杆菌两种有益菌,是市场上最常见、农业种植生产中使用最多的菌种,但很多人连这两种菌哪种是真菌、哪种是细菌都搞不清楚,也有很多人也不知道哈茨木霉菌和枯草芽孢杆菌二者分别有哪些差别和作用,因此,一些农民朋友在购买和使用菌肥或菌剂时,经常在心中或在脑子里存在一个疑问:哈茨木霉菌和枯草芽孢杆菌用到地里后,到底哪个使用效果会更好?今天农技小背篓就给大家说一说哈茨木霉菌和枯草芽孢杆菌这两种菌,大家可以自己去对比、自己去试验。
一、哈茨木霉菌
农技小背篓先给大家说一说哈茨木霉菌。
首先来说,哈茨木霉菌是一种真菌,它是菌也是药,在农药方面来说它属于微生物农药中的真菌杀菌剂范畴,在本质上是一种木霉菌,它在病害菌“战斗”时,不论是在环境适应能力与抗逆性上,还是生存竞争能力上,或者是以菌治菌和综合使用效果上,都可以说是当下最好的菌种类型之一(加“之一”是为了让它骄傲,哈哈)!
我们农业上经常使用的哈茨木霉菌,主要有两种菌株,一种是T-22,一种是G-41。前者在作物根部使用效果比较好,既在作物根部形成预防病害菌侵染根部的隔离保护层,也能分泌对病害菌壁具有消解作用、对病菌繁殖具有抑制作用的抗生素物质和酶物质,可以很好的用来防治作物根部病害;后者在作物叶部使用效果比较好,因为它可以切断病菌能量传递途径、破坏病菌孢子生长、破坏病菌细胞膜,从而对防治作物叶部的*粉白**病、灰霉病、霜霉病、炭疽病等具有很好的作用。

哈茨木霉菌
同时,哈茨木霉菌还能刺激作物根系生长、诱导作物增强抗逆防御能力、改善土壤质量环境、增强作物长势的作用、促进作物吸收养分的效果,这些对提高作物产量、改善作物品质都有很好的帮助作用。
二、枯草芽孢杆菌
上面已经给大家说过,哈茨木霉菌属于真菌,而枯草芽孢杆菌则是一种细菌,不论它们是细菌还是真菌,用到地里、用到作物上都是大有好处的。(为了减少大家阅读的时间,下面把枯草芽孢杆菌的作用简单提炼一下,不详细介绍了)
首先来说,枯草芽孢杆菌是国内使用最多的一个菌种,不论是生产菌肥还是生产单一菌剂或复配性菌剂,使用枯草芽孢杆菌的成本都相对较低。

枯草芽孢杆菌
其次来说,枯草芽孢杆菌的主要作用体现在:①提高土壤中难溶性磷的分解与被作物根系吸收;②促进土壤中有机质的加速分解转化与吸收;③提高有益厌氧菌的活性与数量、分泌枯草菌素等活性物质,分泌对病害菌细胞壁、对根结线虫卵具有溶解作用的几丁质酶,以此起到抑制病害菌繁殖生长、防治土传病害与根结线虫的作用;④在土壤中分解生成对作物根系生长具有刺激促进作用的吲哚乙酸物质,以此促进根系发育;⑤提高土壤的抗逆性、改善土壤质量。
三、哈茨木霉菌与枯草芽孢杆菌
1、哈茨木霉菌是真菌,枯草芽孢杆菌是细菌,二者的作用机制和使用大体上差不多,都是通过菌群优势发挥作用,都是通过强空间竞争性、强拮抗反应、强溶菌作用以及分泌抑菌物质、分泌刺激作物生长(根系)物质、诱导作物增强抗逆抗病免疫力发挥作用的,而且二者都有一定的根结线虫防治效果。

2、哈茨木霉菌会长菌丝,菌群繁殖生长速度快,枯草芽孢杆菌不会长菌丝(长毛的菌肥说明质量不合格),菌群繁殖生长速度慢。
3、哈茨木霉菌可以寄生在其他病害菌上存活,也可以通过寄生病害菌上汲取营养而杀菌,而枯草芽孢杆菌没有这种寄生存活或杀菌的功能。
4、哈茨木霉菌对环境的适应能力与抗逆性,要比枯草芽孢杆菌对环境的适应能力和抗逆性要强,在不良环境条件下使用哈茨木霉菌要比使用枯草芽孢杆菌效果好,因为哈茨木霉菌更容易存活和繁殖。

5、哈茨木霉菌使用到土壤中的繁殖快、菌群规模扩大快且存活能力强,所以在见效速度、持续有效期上会更好,与哈茨木霉菌相比,枯草芽孢杆菌在这一点上要略逊一筹。
6、哈茨木霉菌的综合效果要比枯草芽孢杆菌的综合效果好,比如说见效速度、有效期、杀菌治病、提高肥料利用率等,但不代表枯草芽孢杆菌使用效果不好,只是二者相比之下在促长、促根、壮棵、增产、防病、杀菌、治病以及改良土壤等方面的综合效果,略比哈茨木霉菌差那么一点点罢了!如果把枯草芽孢杆菌与地衣芽孢杆菌一起使用,在抑菌防治病害方面的效果会大幅提升。

7、哈茨木霉菌防治土传性真菌病害效果和促进发芽出苗方面比枯草芽孢杆菌效果好,枯草芽孢杆菌防治作物叶部病害效果要比哈茨木霉菌效果好(这一点是个人体会,大家不妨自己试试对比一下)。
8、哈茨木霉菌与枯草芽孢杆菌使用后的效果,都与使用时机、使用温度、使用湿度、使用方法等有密切的关系。
9、对比哈茨木霉菌与枯草芽孢杆菌二者的使用效果时,既要在同等含量菌数的条件下进行,也要确保二者有效活菌数在同等条件下;除此之外,即使同等有效活菌数的菌肥菌剂,因为哈茨木霉菌繁殖快、存活性强,所以在使用一段时间后,土壤中的哈茨木霉菌的数量会比枯草芽孢杆菌的数量多很多,这样也是不容易对比出实际效果的。

10、在使用哈茨木霉菌与枯草芽孢杆菌时,建议把二者搭配起来使用,但建议大家把哈茨木霉菌和枯草芽孢杆菌一前一后间隔2-3天使用,如果把二者一起使用,枯草芽孢杆菌分泌的枯草菌素等物质可能会对哈茨木霉菌的萌发生长产生一定的抑制作用。
11、在哈茨木霉菌与枯草芽孢杆菌的使用上,二者可以广泛应用在各类土壤和作物上,也可以在作物的各个生长阶段使用,但以在播种前一周、苗床期、定植后一周、病害发生前一周、病病发生初期、根系生长发育不良时使用效果最好,最佳使用环境为土壤PH值5-7.5、温度15-28度、田间湿润且不能太干燥,在使用方法上可以用来基施、冲施、蘸根、灌根、拌种、喷雾(温湿度适宜的大棚内使用),基施用量每亩1-2公斤左右,冲施、滴灌每次每亩500克或稀释300倍左右(一个生长季使用2-3次左右),拌种可以每60-80克拌种子100斤左右,淋浇可以掌握在每平方米苗床土壤2-4克左右,蘸根的稀释浓度掌握在30-60倍左右,淋灌根部浓度可以掌握在200-300倍左右成株每棵200-300毫升左右、苗期每棵150-200毫升左右)。

12、哈茨木霉菌与枯草芽孢杆菌不可在高温强光环境、田间干旱缺水以及温度过低的情况下使用,使用前如果土壤比较干旱,则应当先浇小水补湿后再使用,使用后一周内应当保持土壤始终湿润,普通瓜果蔬菜建议每隔2-3个月为土壤补充1次。
13、哈茨木霉菌与枯草芽孢杆菌应当尽量避免与高浓度肥料、杀菌剂、杀虫剂、除草剂等一起使用,但是,因为哈茨木霉菌是真菌,所以可以和部分防治细菌的杀菌剂一起使用,因为枯草芽孢杆菌是细菌,所以可以和部分防治真菌的杀杀菌剂一起使用。
14、把哈茨木霉菌、枯草芽孢杆菌与腐熟有机肥、腐殖酸等一起使用,可以加快菌在土壤中的繁殖速度、提高菌在土壤中的活性。
点击上方“关注”农技小背篓
每日了解更多新鲜农业种植知识